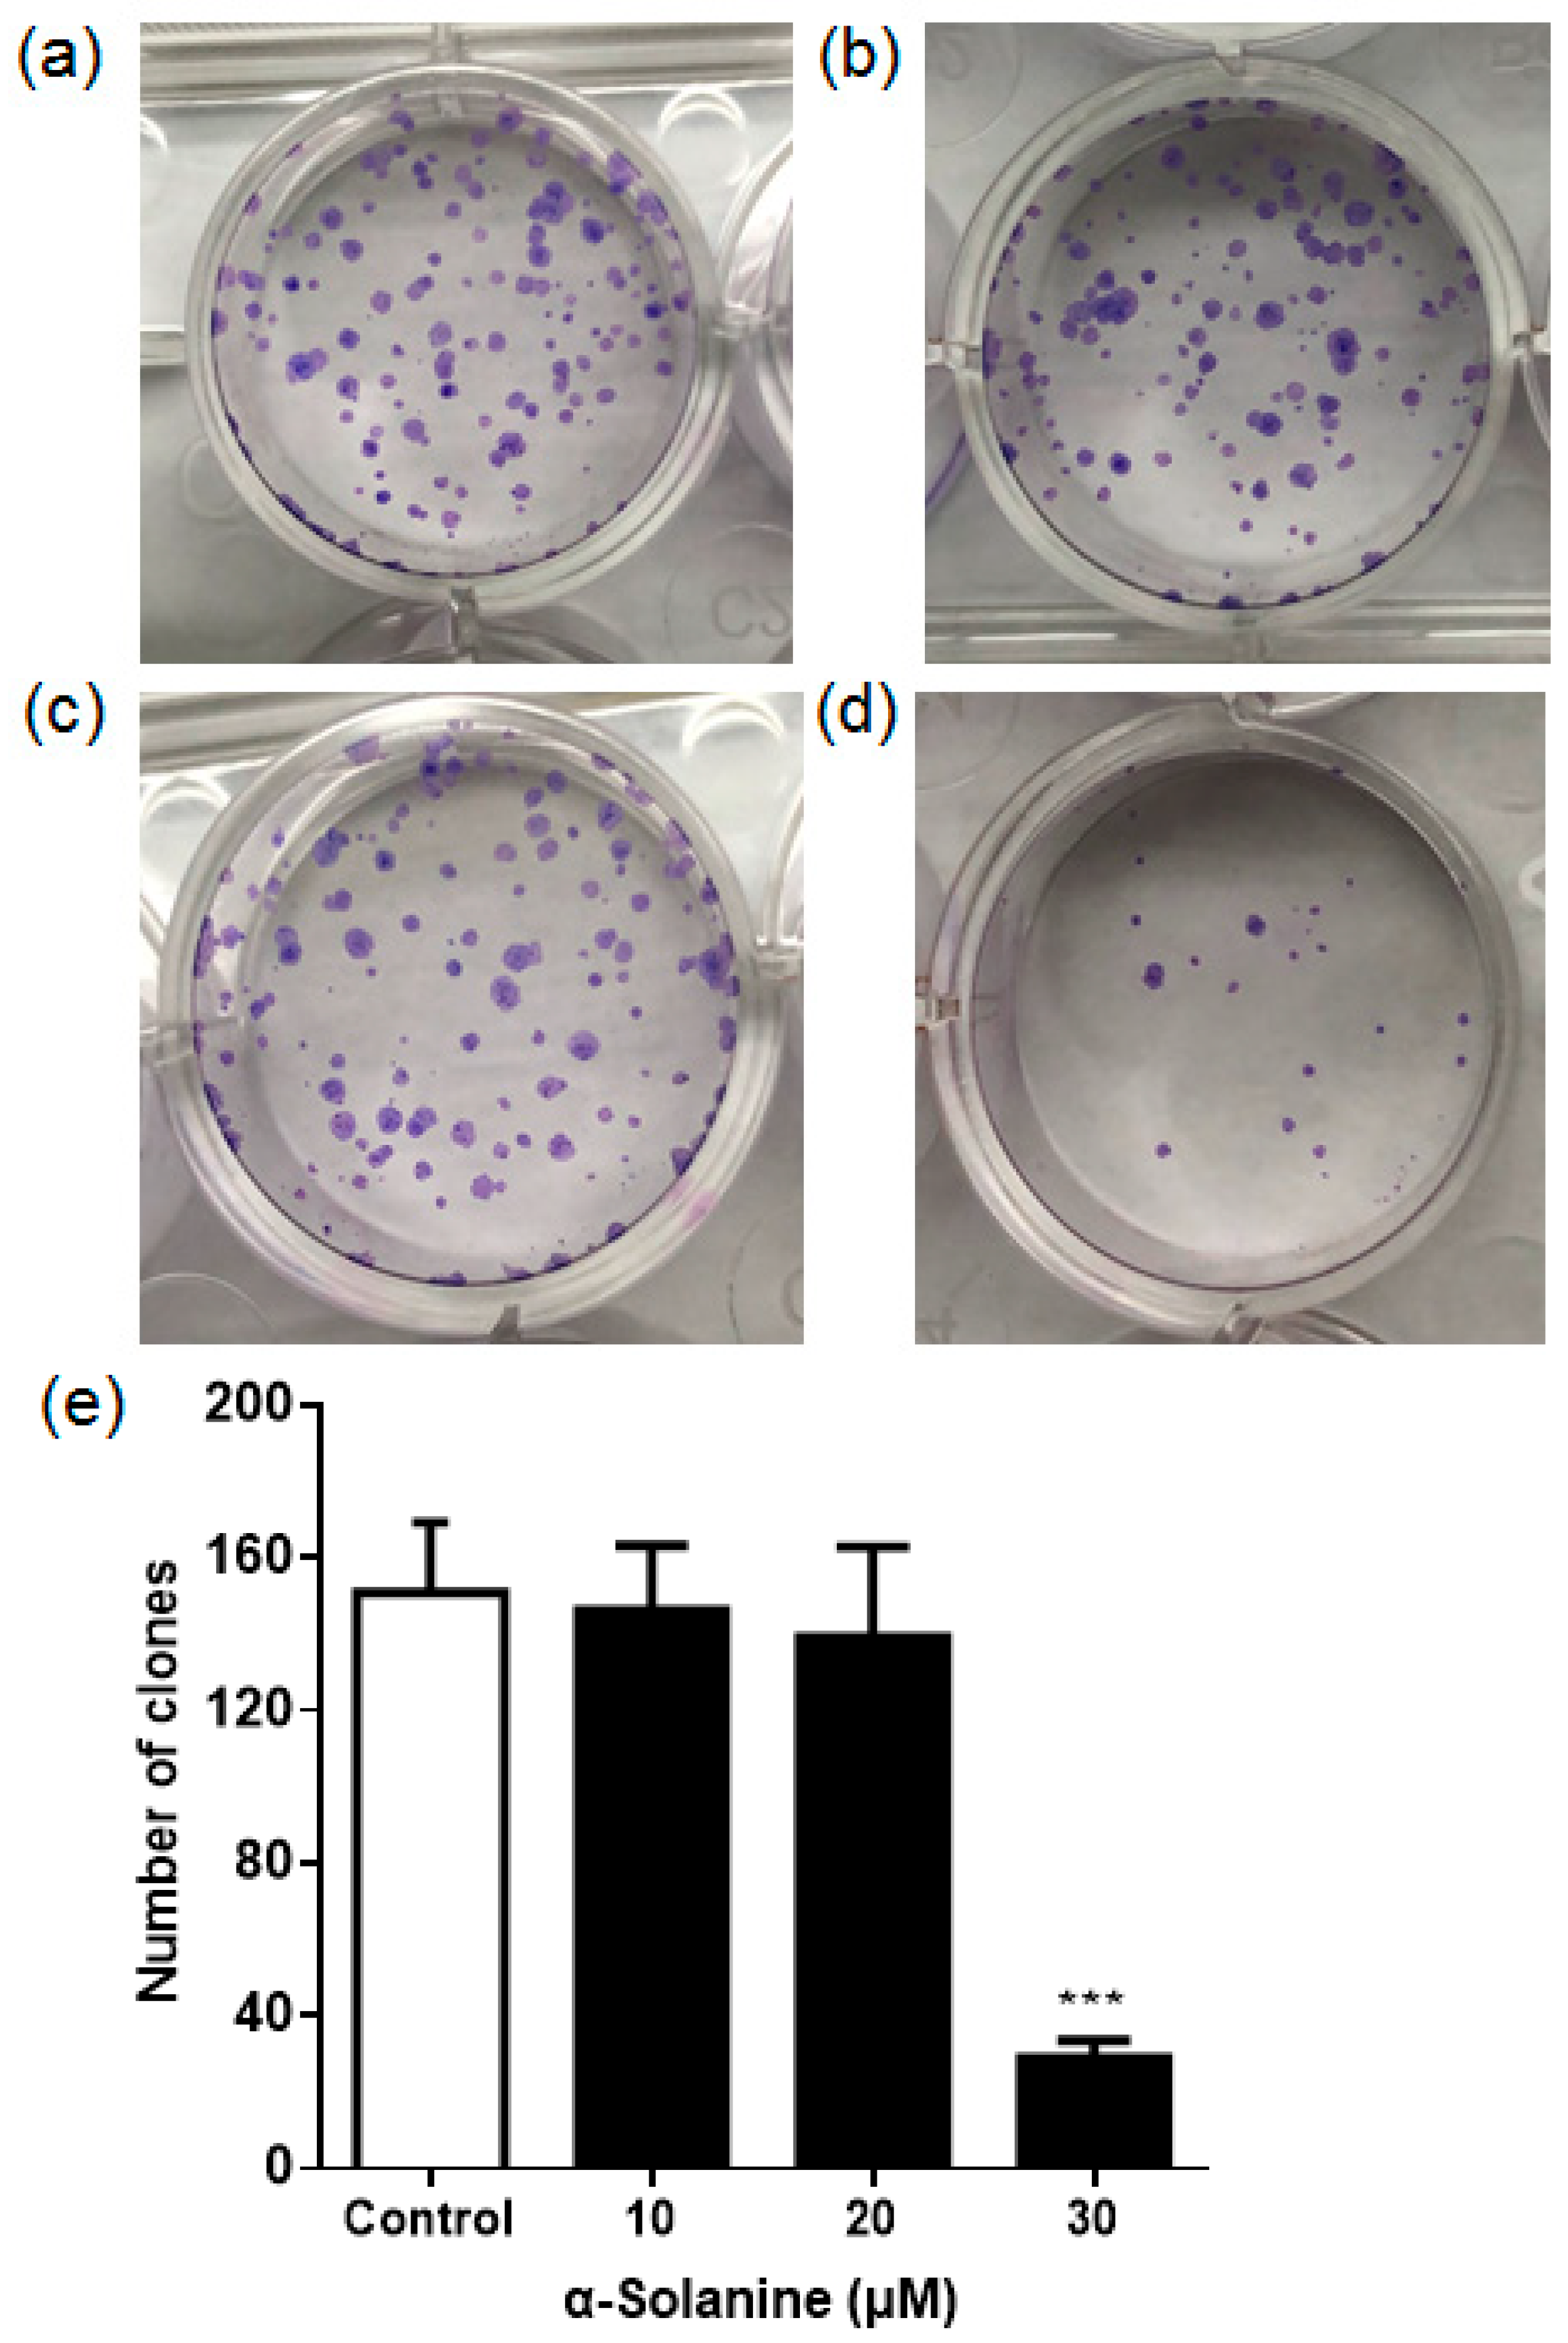
Toxins 13 00210 g002 Toxins 13 00210 g002

α-Solanine Inhibits Proliferation, Invasion, and Migration, and Induces Apoptosis in Human Choriocarcinoma JEG-3 Cells In Vitro and In Vivo
Abstract
1. Introduction
2. Results
2.1. α-Solanine Reduced the Cell Viability of JEG-3 Cells
2.2. α-Solanine Suppressed the Colony Formation of JEG-3 Cells
2.3. α-Solanine Induced Apoptosis in JEG-3 Cells
2.4. α-Solanine Inhibited the Migration and Invasion of JEG-3 Cells and Downregulated the Expression of MMP-2/9
2.5. α-Solanine Inhibited JEG-3 Cell Proliferation In Vivo
3. Discussion
4. Materials and Methods
4.1. Chemicals and Reagents
4.2. Cell Culture and Proliferation Assay
4.3. Colony Formation Assay
4.4. Annexin V and PI Staining
4.5. Western Blot
4.6. Wound Healing Assay
4.7. Transwell Invasion Assay
4.8. Reverse Transcription and Quantitative RT-PCR
4.9. Zymography
4.10. Animal Experiments
4.10.1. Animal Treatment
4.10.2. Animal Sacrifice and Tissue Sampling
4.10.3. TUNEL Assay
4.11. Statistical Analysis
Author Contributions
Funding
Institutional Review Board Statement
Informed Consent Statement
Data Availability Statement
Conflicts of Interest
References
- Hui, P. Gestational trophoblastic tumors: A timely review of diagnostic pathology. Arch. Pathol. Lab. Med. 2019, 143, 65–74. [Google Scholar] [CrossRef]
- Vilotic, A.; Bojic-Trbojevic, Z.; Vicovac, L.; Jovanovic Krivokuca, M. Macrophage migration inhibitory factor is differentially expressed in normal and choriocarcinoma trophoblast cells. Neoplasma 2020, 67, 323–332. [Google Scholar] [CrossRef] [PubMed]
- Bishop, B.N.; Edemekong, P.F. StatPearls [Internet]. In Choriocarcinoma; StatPearls Publishing: Treasure Island, FL, USA, 2020. Available online: https://www.ncbi.nlm.nih.gov/books/NBK535434/ (accessed on 12 March 2021).
- Petit, J.; Wakx, A.; Gil, S.; Fournier, T.; Auzeil, N.; Rat, P.; Laprévote, O. Lipidome-wide disturbances of human placental JEG-3 cells by the presence of MEHP. Biochimie 2018, 149, 1–8. [Google Scholar] [CrossRef]
- Ngan, H.Y.S.; Seckl, M.J.; Berkowitz, R.S.; Xiang, Y.; Golfier, F.; Sekharan, P.K.; Lurain, J.R.; Massuger, L. Update on the diagnosis and management of gestational trophoblastic disease. Int. J. Gynaecol. Obstet. 2018, 143 (Suppl. 2), 79–85. [Google Scholar] [CrossRef] [PubMed]
- Friedman, M. Potato glycoalkaloids and metabolites: Roles in the plant and in the diet. J. Agric. Food Chem. 2006, 54, 8655–8681. [Google Scholar] [CrossRef] [PubMed]
- Koffi, G.Y.; Remaud-Simeon, M.; Due, A.E.; Combes, D. Isolation and chemoenzymatic treatment of glycoalkaloids from green, sprouting and rotting Solanum tuberosum potatoes for solanidine recovery. Food Chem. 2017, 220, 257–265. [Google Scholar] [CrossRef] [PubMed]
- Hassan, S.H.; Gul, S.; Zahra, H.S.; Maryam, A.; Shakir, H.A.; Khan, M.; Irfan, M. Alpha solanine: A novel natural bioactive molecule with anticancer effects in multiple human malignancies. Nutr. Cancer 2020, 1–12. [Google Scholar] [CrossRef] [PubMed]
- Kawamoto, Y.; Morinaga, Y.; Kimura, Y.; Kaku, N.; Kosai, K.; Uno, N.; Hasegawa, H.; Yanagihara, K. TNF-α inhibits the growth of Legionella pneumophila in airway epithelial cells by inducing apoptosis. J. Infect. Chemother. 2017, 23, 51–55. [Google Scholar] [CrossRef]
- Mondal, A.; Bennett, L.L. Resveratrol enhances the efficacy of sorafenib mediated apoptosis in human breast cancer MCF7 cells through ROS, cell cycle inhibition, caspase 3 and PARP cleavage. Biomed. Pharmacother. 2016, 84, 1906–1914. [Google Scholar] [CrossRef]
- Pawlak, A.; Gładkowski, W.; Mazur, M.; Henklewska, M.; Obmińska-Mrukowicz, B.; Rapak, A. Optically active stereoisomers of 5-(1-iodoethyl)-4-(4′-isopropylphenyl) dihydrofuran-2-one: The effect of the configuration of stereocenters on apoptosis induction in canine cancer cell lines. Chem. Biol. Interact. 2017, 261, 18–26. [Google Scholar] [CrossRef]
- Roberts, A.W.; Davids, M.S.; Pagel, J.M.; Kahl, B.S.; Puvvada, S.D.; Gerecitano, J.F.; Kipps, T.J.; Anderson, M.A.; Brown, J.R.; Gressick, L.; et al. Targeting BCL2 with venetoclax in relapsed chronic lymphocytic leukemia. N. Engl. J. Med. 2016, 374, 311–322. [Google Scholar] [CrossRef] [PubMed]
- Delbridge, A.R.; Grabow, S.; Strasser, A.; Vaux, D.L. Thirty years of BCL-2: Translating cell death discoveries into novel cancer therapies. Nat. Rev. Cancer 2016, 16, 99–109. [Google Scholar] [CrossRef]
- Mohsenikia, M.; Alizadeh, A.M.; Khodayari, S.; Khodayari, H.; Kouhpayeh, S.A.; Karimi, A.; Zamani, M.; Azizian, S.; Moagheghi, M.A. The protective and therapeutic effects of alpha-solanine on mice breast cancer. Eur. J. Pharmacol. 2013, 718, 1–9. [Google Scholar] [CrossRef]
- Mohsenikia, M.; Farhangi, B.; Alizadeh, A.M.; Khodayari, H.; Khodayari, S.; Khori, V.; Arjmand Abbassi, Y.; Vesovic, M.; Soleymani, A.; Najafi, F. Therapeutic effects of dendrosomal solanine on a metastatic breast tumor. Life Sci. 2016, 148, 260–267. [Google Scholar] [CrossRef] [PubMed]
- Chen, Z.; Li, C.; Yuan, A.; Gu, T.; Zhang, F.; Fan, X.; Wu, X.; Xiong, X.; Yang, Q. α-Solanine causes cellular dysfunction of human trophoblast cells via apoptosis and autophagy. Toxins 2021, 13, 67. [Google Scholar] [CrossRef] [PubMed]
- Park, S.; Park, M.Y.; Song, G.; Lim, W. Alpha-solanine inhibits cell proliferation via mitochondrial dysfunction and inhibin synthesis in mouse testis In vitro and In vivo. Chemosphere 2019, 235, 271–279. [Google Scholar] [CrossRef]
- Lin, T.; Oqani, R.K.; Lee, J.E.; Kang, J.W.; Kim, S.Y.; Cho, E.S.; Jeong, Y.D.; Baek, J.J.; Jin, D.I. α-Solanine impairs oocyte maturation and quality by inducing autophagy and apoptosis and changing histone modifications in a pig model. Reprod. Toxicol. 2018, 75, 96–109. [Google Scholar] [CrossRef]
- Wang, S.; Panter, K.E.; Gaffield, W.; Evans, R.C.; Bunch, T.D. Effects of steroidal glycoalkaloids from potatoes (Solanum tuberosum) on in vitro bovine embryo development. Anim. Reprod. Sci. 2005, 85, 243–250. [Google Scholar] [CrossRef]
- Zhang, F.; Yang, R.; Zhang, G.; Cheng, R.; Bai, Y.; Zhao, H.; Lu, X.; Li, H.; Chen, S.; Li, J.; et al. Anticancer function of α-solanine in lung adenocarcinoma cells by inducing microRNA-138 expression. Tumor Biol. 2016, 37, 6437–6446. [Google Scholar] [CrossRef] [PubMed]
- Wang, L.; Sun, Q.Q.; Zhang, S.J.; Du, Y.W.; Wang, Y.Y.; Zang, W.Q.; Chen, X.N.; Zhao, G.Q. Inhibitory effect of α-solanine on esophageal carcinoma in vitro. Exp. Ther. Med. 2016, 12, 1525–1530. [Google Scholar] [CrossRef][Green Version]
- Sun, H.; Lv, C.; Yang, L.; Wang, Y.; Zhang, Q.; Yu, S.; Kong, H.; Wang, M.; Xie, J.; Zhang, C.; et al. Solanine induces mitochondria-mediated apoptosis in human pancreatic cancer cells. Biomed Res. Int. 2014, 2014, 805926. [Google Scholar] [CrossRef]
- Hasanain, M.; Bhattacharjee, A.; Pandey, P.; Ashraf, R.; Singh, N.; Sharma, S.; Vishwakarma, A.L.; Datta, D.; Mitra, K.; Sarkar, J. α-Solanine induces ROS-mediated autophagy through activation of endoplasmic reticulum stress and inhibition of Akt/mTOR pathway. Cell Death Dis. 2015, 6, e1860. [Google Scholar] [CrossRef]
- Nawab, A.; Thakur, V.S.; Yunus, M.; Ali Mahdi, A.; Gupta, S. Selective cell cycle arrest and induction of apoptosis in human prostate cancer cells by a polyphenol-rich extract of Solanum nigrum. Int. J. Mol. Med. 2012, 29, 277–284. [Google Scholar]
- Grümmer, R.; Donner, A.; Winterhager, E. Characteristic growth of human choriocarcinoma xenografts in nude mice. Placenta 1999, 20, 547–553. [Google Scholar] [CrossRef]
- Chen, Z.; Zhang, J.; Yuan, A.; Han, J.; Tan, L.; Zhou, Z.; Zhao, H.; Su, R.; Huang, B.; Wang, B.; et al. R-spondin3 promotes the tumor growth of choriocarcinoma JEG-3 cells. Am. J. Physiol. Cell Physiol. 2020, 318, C664–C674. [Google Scholar] [CrossRef] [PubMed]
- Choe, K.N.; Moldovan, G.L. Forging ahead through darkness: PCNA, still the principal conductor at the replication fork. Mol. Cell 2017, 65, 380–392. [Google Scholar] [CrossRef] [PubMed]
- Yan, X.; Li, M.; Chen, L.; Peng, X.; Que, Z.J.; An, H.M.; Shen, K.P.; Hu, B. α-Solanine inhibits growth and metastatic potential of human colorectal cancer cells. Oncol. Rep. 2020, 43, 1387–1396. [Google Scholar] [CrossRef]
- Chen, J.; Thompson, L.U. Lignans and tamoxifen, alone or in combination, reduce human breast cancer cell adhesion, invasion and migration in vitro. Breast Cancer Res. Treat. 2003, 80, 163–170. [Google Scholar] [CrossRef] [PubMed]
- Valastyan, S.; Weinberg, R.A. Tumor metastasis: Molecular insights and evolving paradigms. Cell 2011, 147, 275–292. [Google Scholar] [CrossRef] [PubMed]
- Qi, X.K.; Han, H.Q.; Zhang, H.J.; Xu, M.; Li, L.; Chen, L.; Xiang, T.; Feng, Q.S.; Kang, T.; Qian, C.N.; et al. OVOL2 links stemness and metastasis via fine-tuning epithelial-mesenchymal transition in nasopharyngeal carcinoma. Theranostics 2018, 8, 2202–2216. [Google Scholar] [CrossRef] [PubMed]
- Ni, X.; Chen, J.; Lu, F.; Yuan, Z.; Xu, X.; Hu, Z.; Jiang, L. Anti-cancer effect of α-solanine by down-regulating S100P expression in colorectal cancer cells. Recent Pat. Anticancer Drug Discov. 2018, 13, 240–247. [Google Scholar] [CrossRef]
- Shen, K.H.; Liao, A.C.; Hung, J.H.; Lee, W.J.; Hu, K.C.; Lin, P.T.; Liao, R.F.; Chen, P.S. alpha-Solanine inhibits invasion of human prostate cancer cell by suppressing epithelial-mesenchymal transition and MMPs expression. Molecules 2014, 19, 11896–11914. [Google Scholar] [CrossRef] [PubMed]
- Li, H.; Qiu, Z.; Li, F.; Wang, C. The relationship between MMP-2 and MMP-9 expression levels with breast cancer incidence and prognosis. Oncol. Lett. 2017, 14, 5865–5870. [Google Scholar] [CrossRef] [PubMed]
- Muscella, A.; Vetrugno, C.; Cossa, L.G.; Marsigliante, S. TGF-β1 activates RSC96 Schwann cells migration and invasion through MMP-2 and MMP-9 activities. J. Neurochem. 2020, 153, 525–538. [Google Scholar] [CrossRef] [PubMed]
- Chu, S.C.; Yu, C.C.; Hsu, L.S.; Chen, K.S.; Su, M.Y.; Chen, P.N. Berberine reverses epithelial-to-mesenchymal transition and inhibits metastasis and tumor-induced angiogenesis in human cervical cancer cells. Mol. Pharmacol. 2014, 86, 609–623. [Google Scholar] [CrossRef]
- Koppikar, S.J.; Choudhari, A.S.; Suryavanshi, S.A.; Kumari, S.; Chattopadhyay, S.; Kaul-Ghanekar, R. Aqueous cinnamon extract (ACE-c) from the bark of Cinnamomum cassia causes apoptosis in human cervical cancer cell line (SiHa) through loss of mitochondrial membrane potential. BMC Cancer 2010, 10, 210. [Google Scholar] [CrossRef]
- Śmigielski, J.; Piskorz, Ł.; Talar-Wojnarowska, R.; Malecka-Panas, E.; Jabłoński, S.; Brocki, M. The estimation of metaloproteinases and their inhibitors blood levels in patients with pancreatic tumors. World J. Surg. Oncol. 2013, 11, 137. [Google Scholar] [CrossRef]
- Ma, X.J.; Fu, Y.Y.; Li, Y.X.; Chen, L.M.; Chai, K.; Wang, Y.L. Prostasin inhibits cell invasion in human choriocarcinomal JEG-3 cells. Histochem. Cell Biol. 2009, 132, 639–646. [Google Scholar] [CrossRef] [PubMed]
- Kim, S.; Lee, J.; Jeon, M.; Lee, J.E.; Nam, S.J. Zerumbone suppresses the motility and tumorigenecity of triple negative breast cancer cells via the inhibition of TGF-β1 signaling pathway. Oncotarget 2016, 7, 1544–1558. [Google Scholar] [CrossRef] [PubMed]
- Chang, W.L.; Yang, Q.; Zhang, H.; Lin, H.Y.; Zhou, Z.; Lu, X.; Zhu, C.; Xue, L.Q.; Wang, H. Role of placenta-specific protein 1 in trophoblast invasion and migration. Reproduction 2014, 148, 343–352. [Google Scholar] [CrossRef]
- Wang, L.; Wang, C.; Tao, Z.; Zhao, L.; Zhu, Z.; Wu, W.; He, Y.; Chen, H.; Zheng, B.; Huang, X.; et al. Curcumin derivative WZ35 inhibits tumor cell growth via ROS-YAP-JNK signaling pathway in breast cancer. J. Exp. Clin. Cancer Res. 2019, 38, 1–17. [Google Scholar] [CrossRef] [PubMed]

Publisher’s Note: MDPI stays neutral with regard to jurisdictional claims in published maps and institutional affiliations. |
© 2021 by the authors. Licensee MDPI, Basel, Switzerland. This article is an open access article distributed under the terms and conditions of the Creative Commons Attribution (CC BY) license (http://creativecommons.org/licenses/by/4.0/).
Share and Cite
Gu, T.; Yuan, W.; Li, C.; Chen, Z.; Wen, Y.; Zheng, Q.; Yang, Q.; Xiong, X.; Yuan, A. α-Solanine Inhibits Proliferation, Invasion, and Migration, and Induces Apoptosis in Human Choriocarcinoma JEG-3 Cells In Vitro and In Vivo. Toxins 2021, 13, 210. https://doi.org/10.3390/toxins13030210
Gu T, Yuan W, Li C, Chen Z, Wen Y, Zheng Q, Yang Q, Xiong X, Yuan A. α-Solanine Inhibits Proliferation, Invasion, and Migration, and Induces Apoptosis in Human Choriocarcinoma JEG-3 Cells In Vitro and In Vivo. Toxins. 2021; 13(3):210. https://doi.org/10.3390/toxins13030210
Chicago/Turabian StyleGu, Ting, Wei Yuan, Chen Li, Zhilong Chen, Yuting Wen, Qiyi Zheng, Qing Yang, Xingyao Xiong, and Anwen Yuan. 2021. "α-Solanine Inhibits Proliferation, Invasion, and Migration, and Induces Apoptosis in Human Choriocarcinoma JEG-3 Cells In Vitro and In Vivo" Toxins 13, no. 3: 210. https://doi.org/10.3390/toxins13030210
APA StyleGu, T., Yuan, W., Li, C., Chen, Z., Wen, Y., Zheng, Q., Yang, Q., Xiong, X., & Yuan, A. (2021). α-Solanine Inhibits Proliferation, Invasion, and Migration, and Induces Apoptosis in Human Choriocarcinoma JEG-3 Cells In Vitro and In Vivo. Toxins, 13(3), 210. https://doi.org/10.3390/toxins13030210

